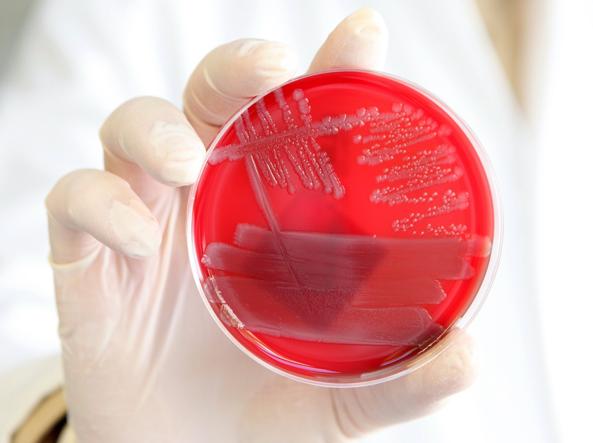

Non si parla d’altro. Dal Global Strike For Future si respira un risveglio delle coscienze sui rischi irreversibili cui andiamo incontro. Come tante formiche indifese al cospetto delle proprie colpe, abbiamo tutti contribuito a creare una Plastisfera.
Questo raccapricciante Leviatano adesso ospita e traghetta più organismi microbici di quelli che l’ecosistema avrebbe dovuto fronteggiare.
Eppure, quotidianamente, continuiamo a contaminare ogni area dell’ambiente terrestre con rifiuti di vario ordine e grado di tossicità.
Nuovi continenti, tossici
Nell’Oceano Pacifico, tra la California e le Hawaii, esiste una massa di detriti.
Ci sono bottiglie di plastica, giocattoli, scarti di oggetti di elettronica, reti da pesca e milioni di detriti galleggiano sull’acqua.

La plastica si disgrega molto lentamente in minuscoli pezzi che vengono naturalmente ingeriti dai pesci, entrando inesorabilmente nella catena alimentare animale e umana.
Essendo, di fatto, la stessa catena alimentare.
Negli ultimi anni quest’area ha ricevuto addirittura un nome: è conosciuta come Great Pacific Garbage Patch, una discarica in cui oggetti quotidiani vengono depositati dalle correnti marine.
Il Great Pacific Garbage Patch è stato scoperto per la prima volta nel 1997 dall’oceanografo Charles Moore, tornato dalla traversata Transpacific Yacht Race, proprio dalla California alle Hawaii.
Stupore, sconcerto, prime prese di posizione teoriche, sotterraneo terrore di essere raggiunti dalle propagini di una resa dei conti, che si vuole ancora rimuovere chiudendo gli occhi.
Ha fatto notizia, e poi… come sempre si è pensato ad altro.
Continuando, si badi bene, a vivere e scartare grossolanamente i propri rifiuti come se quell’orrendo richiamo all’ordine non fosse mai giunto fin dentro casa nostra.
Puoi rimandare ma il tempo non lo farà
Questa famosa frase di Benjamin Franklin racchiude l’esito di quanto avvenne da quel primo avvistamento della spaventosa piattaforma in balia dei venti e delle maree.
Nel 2014, Laurent Lebreton, studioso, ha dichiarato che l’area continuava a crescere in maniera spropositata e il 99,9% di quello che veniva estratto dall’oceano fosse plastica. Da qui il nome isola di plastica.
Laurent inoltre affermò: “Abbiamo trovato anche alcuni oggetti inaspettati, come dei giocattoli di plastica. Ho trovato la scena davvero triste perché i giocattoli potrebbero provenire dallo tsunami che c’è stato in Giappone nel 2011“.
Anche allora, gli esperti sottolinearono l’urgenza della situazione.
Analizzarono i risultati riguardanti la concentrazione di microplastiche nell’area – 1.8 trilioni di pezzi – che si stimava sarebbero aumentate ulteriormente di 30 volte, per un totale di circa 50 trilioni di particelle.
Infine, i ricercatori rimarcarono la necessità di agire rapidamente, attuando misure internazionali sostanziali nel successivo decennio, con l’obiettivo di arrestare il crescente afflusso di rifiuti di plastica negli oceani.
E suggerirono di sostenere iniziative di rimozione, come la pulizia delle coste e degli oceani, per le plastiche esistenti che si accumulano negli oceani e minacciano il benessere della fauna oceanica.
Plastica: un gran bel multi-inquinante
Le potenzialità inquinanti della plastica sono sottovalutate e, sicuramente, sconosciute a tanti. Tutto sommato non è difficile da comprendere.
Quando un derivato sintetico del petrolio, creato in laboratorio con lo scopo di possedere una eccezionale durevolezza, incontra gli agenti atmosferici, i risultati sono fuori dal controllo umano.
E’ quasi un’ancestrale sfida tra Madre Natura e le impennate incoscienti dell’orgoglio umano, che si inventa una supremazia dove presto o tardi troverà una condanna senza appello.
Guardiamolo negli occhi allora questo alleato artificiale che ci è sfuggito di mano.
Quanti tipi di inquinamento idrico comporta la sua stasi galleggiante silenziosa e soffocante?
Inquinamento fisico da plastica
Già il solo stazionamento a pelo d’acqua, fa, della orrida zattera di pattume, un tappo sulla supercifie del corpo idrico.
Impedisce così al mare i normali e fisiologici scambi gassosi con l’atmosfera, creando strati d’acqua a diversa temperatura, innaturali e patologici.
La plastica di per sè è in grado di raggiungere sotto il sole temperature elevate che alterano l’ambiente idrico nel quale si ritrova abbandonata: il mare.

Ma c’è di più.
I rifiuti di plastica dispersi nell’ambiente e nelle acque contribuiscono all’effetto serra e quindi al riscaldamento globale.
La scoperta arriva da un gruppo di ricercatori che ha eseguito numerosi tests nei pressi delle isole Hawaii.
I risultati, pubblicati sulla rivista scientifica PlosOne, sono allarmanti: questo materiale, degradandosi, emette in particolare due gas serra, l’etilene e il metano.
Quest’ultimo è particolarmente potente. Benché resista meno nell’atmosfera rispetto all’anidride carbonica, nel periodo in cui è attivo, produce un riscaldamento 25 volte superiore a quello generato dall’anidride carbonica.
Secondo i ricercatori, il polimero più prolifico in termini di produzione di gas serra, in particolare di quelli sopra citati, è il polietilene.
Il polietilene è già noto per il rilascio di additivi nell’ambiente, sempre a causa del processo di decomposizione.
Questo polimero sintetico è il più usato in assoluto: rappresenta infatti il 36% della plastica prodotta al mondo.
Imballaggi, contenitori, giocattoli, tubi, tappi, sono tutte fonti di polietilene.
L’Europa ha dichiarato che si impegnerà a vietare l’uso di alcuni articoli in plastica monouso, tra cui posate, cannucce, piatti, tamponi e attrezzi da pesca, entro il 2030.
Inquinamento biologico da plastica
Impressionanti sono i numeri di bottiglie e sacchetti di plastica che fluttuano intorno alla terra.
Ma c’è un altro killer conosciuto come “ghost gear” (attrezzo fantasma): una trappola di plastica creata dall’uomo che si annida nei mari come negli oceani.

Secondo le stime della World Animal Protection, ogni anno più di 100.000 balene, delfini, foche e tartarughe marine sono vittime di questi “ghost gear”.
Si tratta di reti da pesca abbandonate, perse e gettate via, che possono impiegare fino a 600 anni per decomporsi e torturano la fauna che vi incappa, fino a morte.
Identica barbarie infliggono le Macroplastiche che derivano da scarti di imballaggio in nylon, cellophane, polistiroli.
Ingeriti od attorcigliati ai loro corpi, finiscono per paralizzarli per sempre o soffocarli in una lenta e dolorosa agonia.

L’inquinamento biologico da macroplastiche, può anche concretizzarsi nella effettiva ingestione di porzioni più piccole di plastica. Le plastiche ingerite, di fatto, in una percentuale crescente, entrano nella struttura organica della fauna ittica che se ne è cibata.
E quindi dei nostri pregiati secondi piatti gourmet.
Siamo a rischio ogni volta che mettiamo nel piatto tonno, pesce spada, sgombro, spigola, granchi, cozze.
Inquinamento chimico da plastica
I rifiuti di plastica che galleggiano in mare vengono degradati dalle reazioni innescate da radiazione UV, idrolisi e microrganismi.
La degradazione della plastica rilascia sostanze chimiche nell’acqua i cui componenti e quantità dipendono dal tipo di composto plastico e dalle condizioni atmosferiche che il rifiuto ha affrontato nel suo drammatico peregrinare marino.

Alcune sostanze chimiche, quali bisfenolo A (Bpa) e antimonio sono prodotti di macerazione della plastica lasciata a mollo per anni in mare.
Il bisfenolo A avvelena tiroide, ovaie, prostata
Il bisfenolo A è una sostanza chimica utilizzata per la produzione di plastiche in policarbonato chiare, rigide e leggere.
Questo materiale è utilizzato soprattutto per preparare stoviglie e contenitori: è un noto componente delle vernici di rivestimento delle lattine alimentari e dei tappi di bottiglia.
Il bisfenolo A altera l’attività dell’apparato endocrino umano, attivando inutilmente e patologicamente i recettori degli ormoni.
L’occupazione errata dei recettori ormonali con composti chimici solo somiglianti agli ormoni richiesti, causa gravi danni ai cicli ormonali.
L’alterazione dei cicli ormonali produce patologie d’organo sia sull’apparato riproduttore maschile sia su quello femminile.
Studi sperimentali hanno dimostrato che il bisfenolo A mima l’azione degli Estrogeni, ormoni essenziali, tra l’altro, nello sviluppo cerebrale, a tal punto che anche dosi minime di questa sostanza possono inibire del tutto l’azione di questi ormoni sulla crescita neuronale.
L’antimonio viaggia da un organo all’altro
L’antimonio è classificato come cancerogeno dall’International Agency for Research on Cancer, organismo internazionale, con sede a Lione, che è parte dell’Organizzazione Mondiale della Sanità.
Questo elemento chimico viene scarsamente assorbito dal tratto gastrointestinale (massimo 15%).
La maggior parte della quota assorbita si accumula nella milza, nel fegato e nel tessuto osseo.
L’antimonio trivalente, a differenza del pentavalente, penetra nei globuli rossi. Viene eliminato con le feci e le urine se in forma trivalente.
La forma pentavalente viene escreta solo con le urine. Esiste, inoltre, la possibilità del passaggio dell’antimonio dal sangue materno a quello fetale.
Gli ingredienti principali delle plastiche
Tra le sostanze più famose solubilizzate in acqua dalle plastiche, ultimamente, sono gli ftalati.
Gli ftalati sono composti utilizzati principalmente come plastificanti per aumentare la flessibilità, la trasparenza, la resistenza e la durata della plastica. Si tende a pensare che le plastiche siano composti stabili.
Ci si fida della competenza e della coscienza etica dei produttori. Si delega alla ricerca industriale la propria sicurezza nel mangiare e nel bere prodotti confezionati.
Se il marchio è rinomato e costoso, ci si sente al riparo da ogni rischio.
Ma la realtà bio-molecolare è un’altra: il legame chimico tra le molecole di bisfenolo A è altamente instabile.
C’è quindi un’elevata probabilità che la sostanza diffonda nell’acqua, nelle bevande o nel cibo che sono a contatto con queste materie plastiche.
Inquinamento microbiologico da plastica
La degradazione della plastica nell’ambiente porta alla formazione di unità più piccole, le Microplastiche, moltiplicando quindi la superficie di contatto del materiale plastico esposta agli insulti atmosferici.
Oppure no.
Gli studi si aspettano e poi susseguendo da anni. Le voci scientifiche si ricorrono e nel settore della ricerca ambientale si sa già.
Microplastiche spiaggiate e mescolate alla sabbia. 
Microplstiche in sospensione in mare.
Le microplastiche sono diventate, a lungo andare, un ottimo substrato di crescita per un elevato ed imprecisato numero di ceppi microbici.
Dovevamo saperlo che la vita si aggrappa a tutto pur di perpetuarsi nei secoli ed oltre.
Conosciamo, infatti, e le abbiamo ammirate con stupore le colonizzazioni di ogni leggendario o moderno relitto affondato, da parte di straordinari organismi marini, in grado di nobilitare e rivestire tutto di variopinta bellezza naturale.


La vita non si ferma mai. Si adatta e va avanti. Sempre.
Ed il mondo batterico, con la sua proverbiale resistenza e tenacia genetica, avrebbe mai potuto restare in dietro in questo incessante processo di colonizzazione e di conquista della Biosfera?
Così, la consapevolezza si trasforma in nome Plastisfera, per indicare la incommensurabile ma provata vita sviluppatasi su quella agghiacciante scialuppa in mezzo al Pacifico.
Plastisfera che minaccia di conquistare la Biosfera, in una grottesca inversione degli ordini di grandezza e delle gerarchie biologiche.
Rischio batteriologico dalla Plastisfera: gli studi
Le plastiche sono la più abbondante forma di detrito marino.
Con una produzione crescente ed impatti documentati, l’influenza della plastica sugli ecosistemi marini è tuttavia scarsamente conosciuta.
Scarsità di dati sperimentali che riguarda specialmente le comunità microbiche. Nel 2013, detriti marini di plastica furono raccolti in diverse zone del Nord Atlantico.
Analizzati con microscopio a scansione elettronico e sequenziate con metodi di ultima generazione, si cercò di caratterizzare le comunità microbiche attaccate ad essi.
I ricercatori svelarono una diversa comunità microbica di eterotrofi, autotrofi, predatori e simbionti.


Inoltre, micro-cavità visibili sulla superficie dei detriti plastici marini risultarono perfettamente adatte alle forme batteriche.
Questa curiosa osservazione suggerì l’ipotesi che i batteri operassero anche una degradazione (idrolisi) attiva dei polimeri di idrocarburi.
La plastica ha una emivita più lunga dei normali substrati galleggianti in mare.
Ha una superficie idrofobica che promuove la colonizzazione e la fornazione di un biofilm, a differenza dei substrati naturali dei livelli più superciali dell’oceano.
Sulla Plastisfera sventola bandiera rossa
Un mese fa, uno studio condotto da Anutthaman Parthasarathy e colleghi ha approfondito la relazione tra microrganismi colonizzatori della Plastisfera e la trasmissione di infezioni.
In alcuni casi, le comunità che formano il biofilm sulle plastiche in mare sono molto diverse da quelle presenti nell’acqua circostante.
Assomigliano di più a quelle che aderiscono ad altre superfici come il vetro.
Eppure, alcuni tipi microbici, incluso il Vibrio spp. ed altri organismi potenzialmente pericolosi, preferiscono colonizzare il polietilene tereftalato (PET), invece del vetro.
Il PET è il materiale plastico più utilizzato nell’imbottigliamento di acque minerali, latte e bevande vegetali.
Questo studio, condotto con metodi di tipizzazione dei dati sulle sequenze genetiche di rRNA 16S (oligo-tipizzazione), ha confermato, per il genere Vibrio, che tali ceppi patogeni per uomo e animali prediligono le plastiche come habitat, rispetto ad altri materiali.

I generi Pseudomonas, Aeromonas, Arcobacter, Zymophilus, Aquabacterium e Campylobacter spp. sono stati associati a plastiche fluviali, le più interessate nel trasporto di patogeni.

L’analisi condotta invece al largo della costa belga ha riportato che i relitti plastici contenevano patogeni per l’uomo come E.coli, Bacillus cereus e Stenotrofomonas maltofilia.
Questi non erano stati trovati invece nelle acque circostanti o nel sedimento costiero.
L’isolamento riduce la biodiversità sulla Plastisfera
I risultati sperimentali, dunque, suggeriscono che la Plastisfera costituisce un potenziale habitat distinto dal contesto marino in cui si trova ed un serbatoio di specie microbiche patogene.
Inoltre, lo studio ha riscontrato una curiosa peculiarità tassonomica: le comunità associate alla plastica hanno dimostrato una ridotta biodiversità di specie, rispetto all’acqua circostante.
Questa perdita di diversità microbiologica è stata correlata ad incrementi nella trasmissione di patologie, in altri contesti.
Saranno tuttavia necessari approfondimenti ulteriori per accertare se il grado di patogenicità dei ceppi con scarsa biodiversità si manifesti nello stesso modo anche nella Plastisfera.
I guai non vengono mai soli: antibiotico-resistenza batterica sulla Plastisfera
Le plastiche venute in contatto con scarichi industriali, contaminati da antibiotici, scarichi agricoli ed ospedalieri potrebbero inoltre ospitare batteri che abbiano acquisito una “resistenza“.
Tra i geni responsabili della antibiotico-resistenza dei microrganismi, l’incidenza dei geni ermB (per la resistenza ai macrolidi, molecole antibatteriche) e tetW (per la resistenza alle tetracicline, farmaci antibatterici) decresceva dopo il trattamento delle acque.
Essi sono stati rilevati in reflui ospedalieri in ingresso nei fiumi e nei corsi d’acqua con sbocco a mare.
Invece, la frequenza dei geni blaTEM (per la resistenza ai beta-lattoni, farmaci antibatterici), qnrS (per la ridotta suscettibilità a fluorochinoloni, antibiotici), ermB e sull (per la resistenza a sulfonamidi, farmaci batteriostatici) incrementava.
La diffusione della antibiotico-resistenza nei reflui da industrie farmaceutiche ha innalzato ulteriormente l’interesse sul tema.
Comuni tipi di microplastiche poliamidiche fungono da vettori per antibiotici molto più rapidamente in acqua potabile che in acqua di mare.
Collegando tutti i dati emersi, le acque reflue, contenendo sia residui di antibiotici che residui microplastici, indurrebbero una selezione dei ceppi batterici resistenti ai farmaci, negli ecosistemi di acqua dolce potabile che tipicamente ricevono questi reflui.
Infine, i ricercatori hanno confutato i dati sulla antibiotico-resistenza dei ceppi microbici adesi alle plastiche disperse in mare, mediante l’uso di un plasmide.
Il plasmide è un elemento genetico extra-cromosomico, presente nelle cellule batteriche, in grado di replicarsi indipendentemente dal DNA dell’ospite.
Inserendo un plasmide ad elevata fluorescenza pKJK5, che promuovesse la resistenza a trimetoprim (farmaco antibatterico) in E.coli, le percentuali di trasferimento del plasmide in batteri associati alle microplastiche crescevano rispetto ai loro omologhi batterici acquatici allo stato libero.
I batteri adesi alle microplastiche e quelli liberi nel mezzo acquoso circostante risultavano, infatti, filogeneticamente diversi.
Patogeni e resistenti agli antibiotici, i residenti della Plastisfera
Il fatto che gli elementi genetici mobili e il trasferimento della resistenza agli antibioti mediante plasmide si verificassero con frequenze crescenti nella Plastisfera, ha fatto “issare bandiera rossa” sul ruolo delle plastiche nell’ospitare e trasmettere batteri antibiotico-resistenti.
Nei campioni marini, i geni attivati dalla associazione batterica alle plastiche sono risultati coinvolti nei sistemi di secrezione delle tossine proteiche.
I sistemi di secrezione batterici sono vie biochimiche con cui i batteri si difendono dal contrattacco del sistema immunitario.
Sulla Plastisfera, i ceppi batterici identificati hanno manifestato tutti gli stessi tipi di secrezione (tipo IV e VI).
Questo dato indica chiaramente che la tossicità crescente sia dovuta ad un trasferimento “orizzontale” di geni, cioè già nella stessa generazione di individui (non solo “verticale” da cellula madre a figli).
L’aggressività della loro patogenicità dipende da questo veloce uniformarsi tra ceppi che si trovano sulla stessa “barca”.

Unica salute, unico mondo
I collegamenti tra antibiotico-resistenza e colonizzazione della plastica necessiteranno di approfondimenti in ambienti di prova più controllati (trial controllati).
In particolare, vi è una scarsità di studi sul meccanismo che collega la colonizzazione delle plastiche alla rapida acquisizione della antibiotico-resistenza da parte dei batteri.
In più, si rendono necessari ed urgenti studi che comparino quantitativamente i responsi fisiologici e i livelli organizzativi di comunità microbiche locali sulle plastiche rispetto ad altre superfici.
Ma, soprattutto, è tempo di chiarire come l’inquinamento plastico induca cambiamenti fisiologici e genetici nei microrganismi.
E’ necessario, però, un approccio olistico più orientato ad una “salute unica tra uomo e ambiente” per ponderare e risolvere l’antibiotico-resistenza e l’inquinamento da plastica.
Con migliore coordinazione tra ricerca ambientale, salute e biologia di base.
Fortunatamente, il tema della resistenza antimicrobica in acque reflue sta ricevendo maggiore attenzione da parte dei ricercatori. Contemporaneamente vengono sviluppati metodi sofisticati di rimozione delle microplastiche dai reflui
L’inquinamento da plastica specialmente nella Biosfera Acquatica è un enorme rischio e la comunità scientifica dovrebbe affrontare questa sfida per combattere la diffusione delle malattie infettive.
Rimedi responsabili e incoscienti baggianate
Secondo le stime più affidabili, nel 2050 avremo prodotto più di 25.000 milioni di tonnellate di rifiuti plastici, di cui la maggior parte di provenienza domestica. Solo una piccola parte verrà riciclata o incenerita.
Nel nostro piccolo, se vogliamo difendere la salute dei mari e preservarne le forme di vita, la prima cosa da fare è cambiare le nostre abitudini di acquisto.
Come?
- Ridurre: optare per prodotti con meno imballaggi (borse di stoffa).
- Riusare: scegliere il vuoto a rendere, il vetro al posto della plastica.
- Riciclare: selezionare i rifiuti, rispettare la raccolta differenziata.
- Recuperare: produrre oggetti diversi dalla loro funzione originale, inventare nuovi utilizzi.
Nuove destinazioni delle plastiche, ovviamente lontane dal mare
Recuperare: produrre oggetti diversi dalla loro funzione originale, inventare nuovi utilizzi…
E’ quello che avrà guidato, per due anni, un gruppo di piccoli studenti guidati da un professore di Tecnica, quando è stato ideato un nuovo gigantesco detrito da rimettere in mare.
Ignorando del tutto il più grave tipo di inquinamento da plastica: l’inquinamento chimico da rilascio di ftalati, bisfenolo A e antimonio.
Cancerogeni ed interferenti endocrini per la fauna ittica e per l’uomo.
In Puglia, in particolare nel pregiato Salento, meta turistica arcinota per lo splendore delle sue acque costiere, c’è chi crede di lanciare messaggi ecologisti originali rimettendo la plastica a mollo di fronte ad una spiaggia.
Proprio così.
La plastica faticosamente raccolta a seguito delle mareggiate, in gruppi di associazioni e volontari di ogni età, farà un nuovo tossico ammollo in mare.
Questa estate 2019, sottoforma di L’imponente imballo di plastica verrà esposto a nuova solubilizzazione dei propri ftalati nelle turchesi acque della spiaggia di Santa Maria al Bagno, Nardò (Lecce).

Un nuovo detrito di plastica galleggiante. Ottimo messaggio anti-inquinamento per le giovanissime generazioni, non credete?
Inversione di marcia solo se mondiale
Se 17 milioni di tonnellate di plastica sono state trovate perfino nelle remote e sperdute isole Pitcairn, in pieno Oceano Pacifico è evidente che il contrasto all’avvelenamento dei mari causato da questa “zuppa di plastica globale” non può essere demandato solo all’azione dei singoli.
Progetti come The Ocean Cleanup ideato dal giovanissimo Boyan Slat, #RethinkPlastic del network Plastic Oceans, oppure attività di sensibilizzazione promosse da organizzazioni internazionali come Greenpeace da sole non bastano.
Questi interventi, pur necessari, incidono sugli effetti e non sulle cause del fenomeno.
Le decisioni prese dai singoli stati e dalla comunità internazionale sono le uniche che possono abbattere drasticamente l’inquinamento dei mari causato dai rifiuti plastici.
Iniziative che devono essere guidate da principi di salvaguardia e contenimento, per ridurre in primo luogo quella parte maggioritaria di plastica che dalla terra finisce in mare.
Ripulendo i fiumi, ad esempio, che sono tra le principali fonti di rilascio di materiali plastici nelle acque di mari ed oceani.
Purtroppo una recente risoluzione dell’Enviromental Assembly delle Nazioni Unite dedicata al tema è stata rimandata al mittente da parte di Stati Uniti, Cina ed India, i maggiori produttori mondiali di rifiuti plastici.

La strada è quindi tutta in salita perché, alle necessarie esigenze di salvaguardia e mantenimento della vita degli oceani, si accostano interessi economici ed industriali che non vedono di buon occhio controlli più stringenti ed efficaci.
Una goccia di civiltà in un oceano di spazzatura
L’approvazione della legge che ha imposto il pagamento degli shopper biodegradabili e compostabili dal 1° Gennaio 2018 (direttiva 2015/720 dell’Unione Europea) è solo un primo passo verso la riduzione dell’uso di plastica da imballaggio.
Tuttavia, prima di percepire una reale inversione di tendenza, la strada da percorrere è ancora lunga.
E’ evidente, comunque, che senza un deciso cambiamento di abitudini d’acquisto, corrette pratiche di riciclo, riduzione, recupero, riutilizzo degli oggetti in plastica, ci troveremo sempre al punto di partenza, in un eterno gioco dell’oca.
Possiamo andare in spiaggia a caccia di plastica.
Oppure possiamo andare a rilassarci a mare, evitando che la plastica ci finisca dentro.
La scelta dipende sempre da noi.